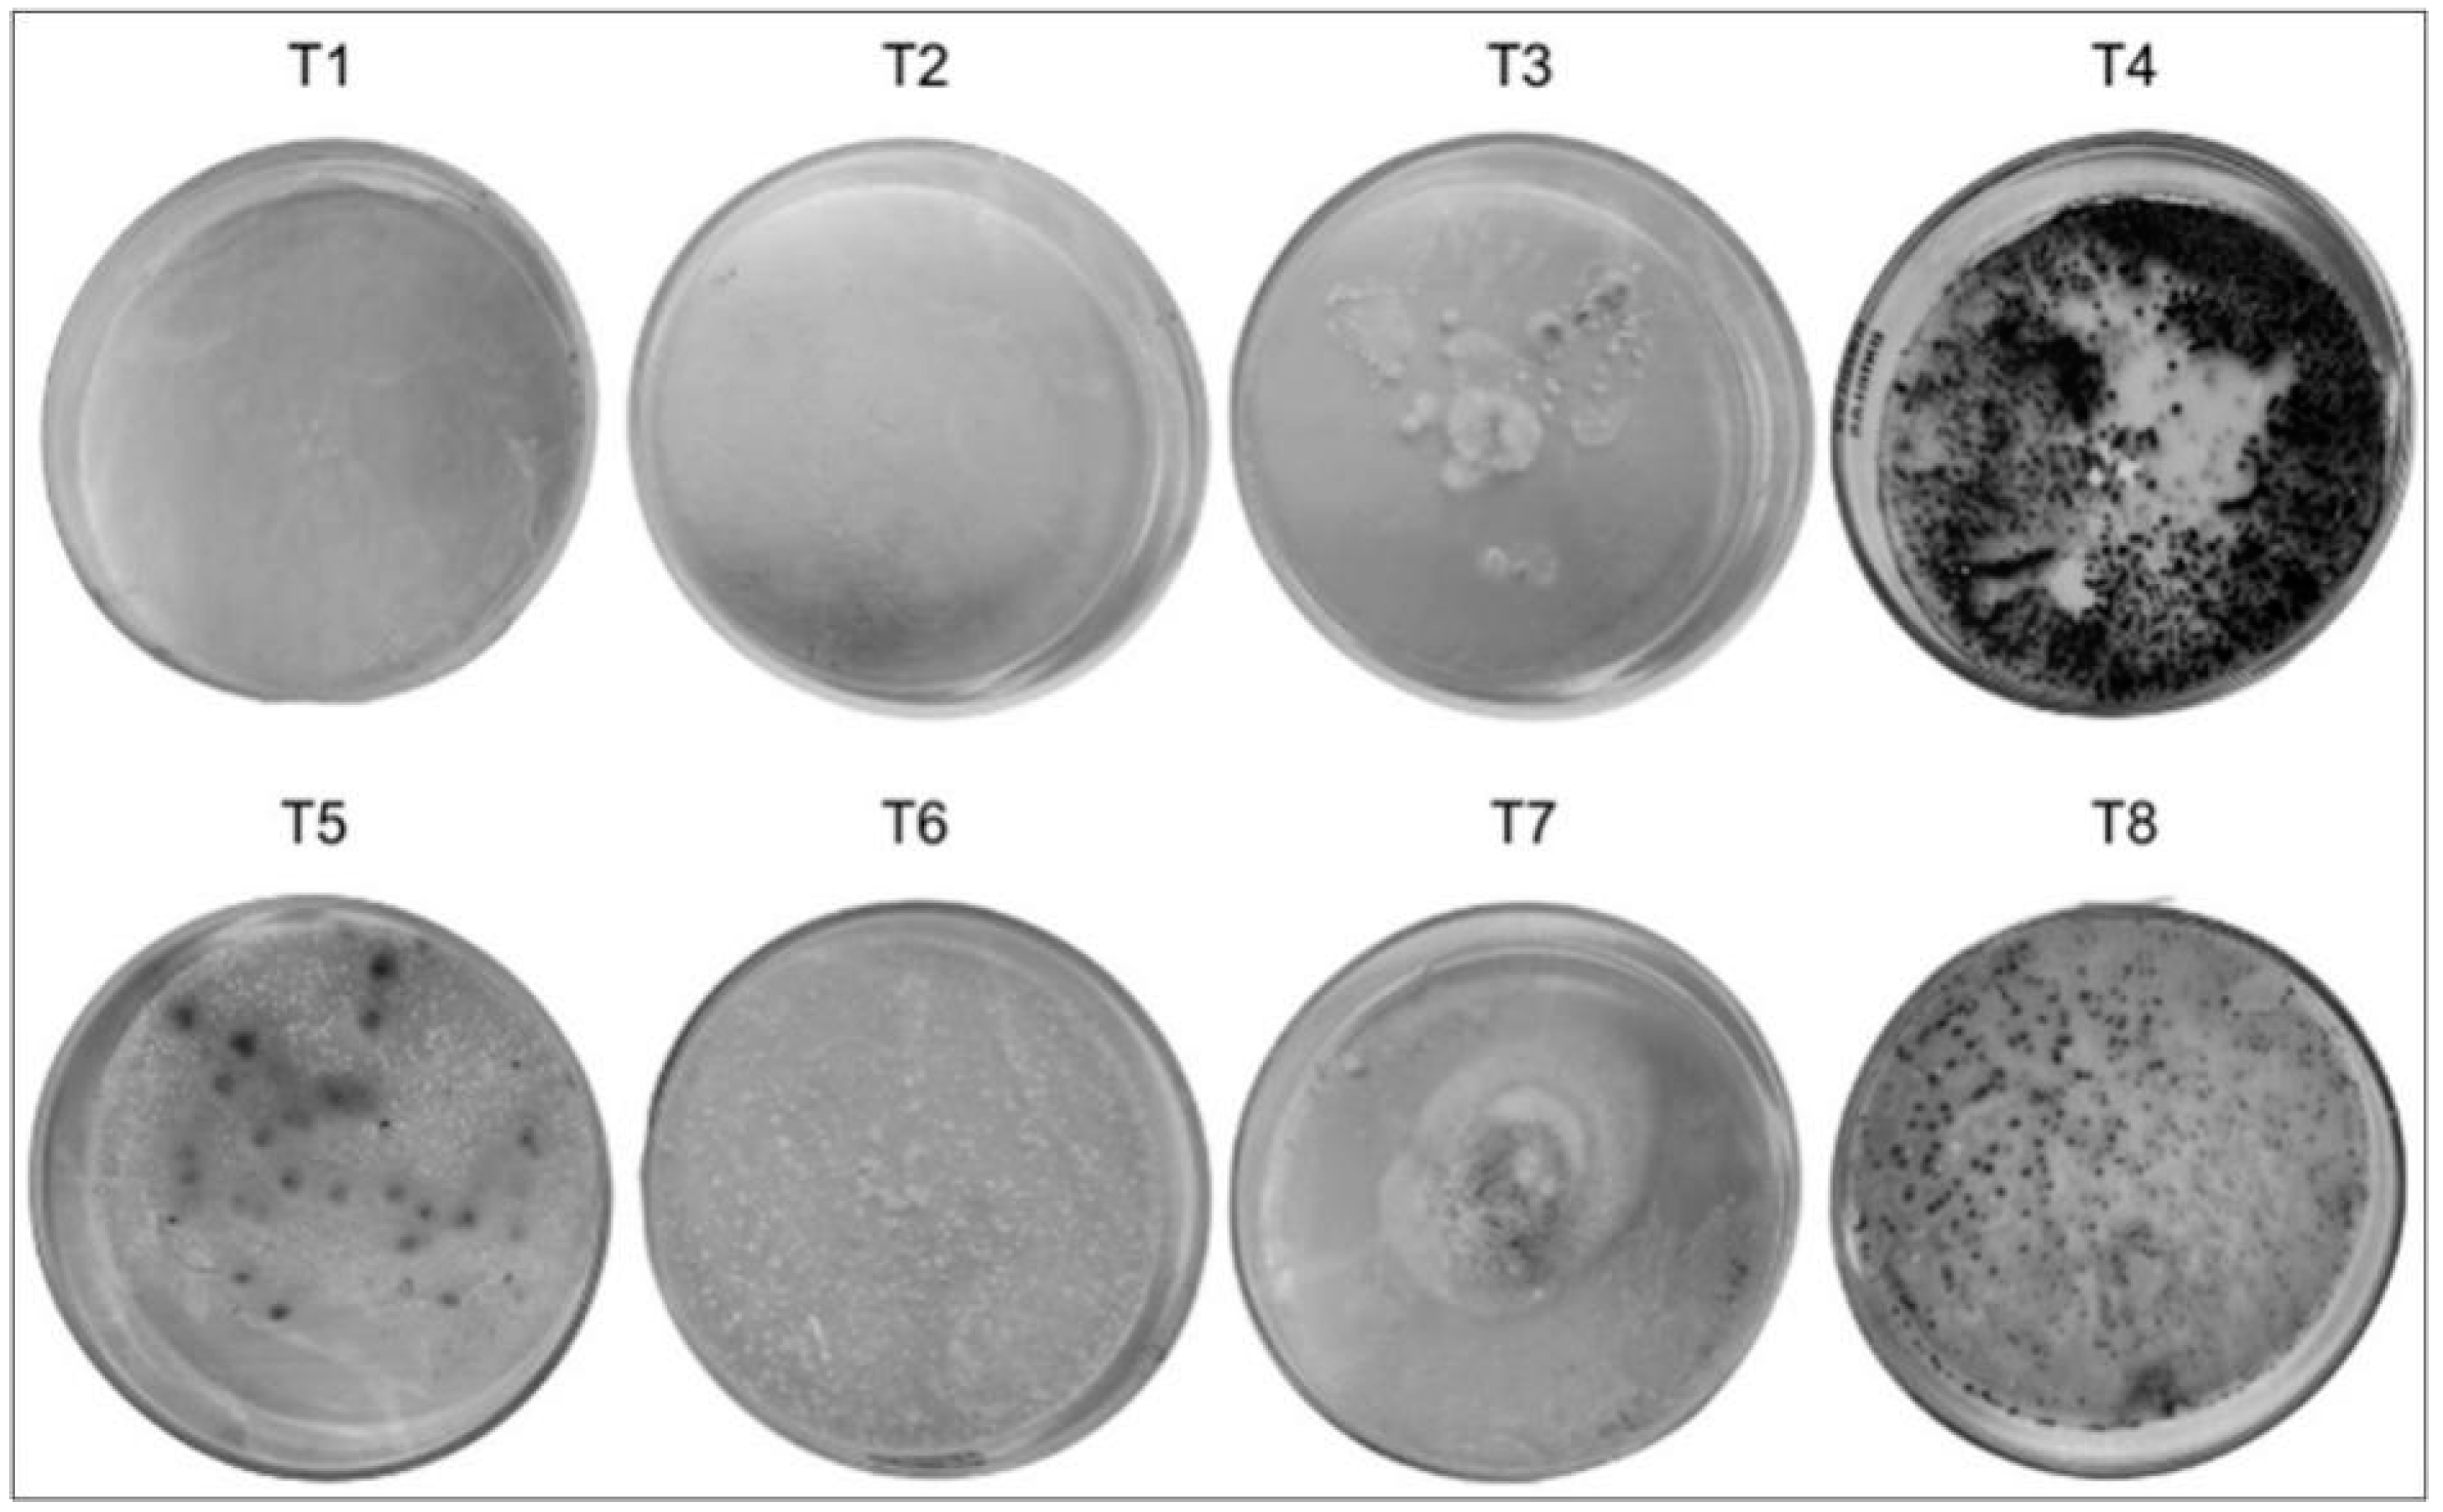

Development of Natural Fungicidal Agricultural Defensives Using Microbial Glycolipid and Vegetable Oil Blends
Abstract
1. Introduction
2. Materials and Methods
2.1. Microorganism, Maintenance, and Inoculum
2.2. Biosurfactant Production
2.3. Surface Tension Determination
2.4. Biosurfactant Extraction
2.5. Critical Micelle Concentration (CMC) Determination
2.6. Thin Layer Chromatography (TLC)
2.7. Blends of Natural Agricultural Defensives
2.8. Assessment of the Antifungal Potential of the Formulated Agricultural Defensives
2.9. Determination of the Phytotoxicity of Agricultural Defensives Blends Using the Plate Germination Test
2.10. Determination of the Phytotoxicity of Agricultural Defensive Blends in the Seedbed
2.11. Determination of the Dispersion Capacity (Spread) of Blends on the Surface
2.12. Post-Harvest Shelf-Life Test
2.13. Statistical Analysis
3. Results and Discussion
3.1. Biosurfactant Production, CMC, and TLC
3.2. Antifungal Potential of Natural Agricultural Defensives
3.3. Phytotoxicity of Formulated Agricultural Defensives
3.4. Germination and Growth in Seedbed
3.5. Dispersion Capacity (Spreading) of Blends on the Surface
3.6. Post-Harvest Shelf-Life
4. Conclusions
Author Contributions
Funding
Informed Consent Statement
Data Availability Statement
Acknowledgments
Conflicts of Interest
References
- FAO. The State of Food Security and Nutrition in the World 2023; FAO: Rome, Italy; IFAD: Rome, Italy; UNICEF: New York, NY, USA; WFP: Rome, Italy; WHO: Geneva, Switzerland, 2023; ISBN 978-92-5-137226-5. [Google Scholar]
- Hezakiel, H.E.; Thampi, M.; Rebello, S.; Sheikhmoideen, J.M. Biopesticides: A green approach towards agricultural pests. Appl. Biochem. Biotechnol. 2023, 196, 5533–5562. [Google Scholar] [CrossRef] [PubMed]
- EMBRAPA. Visão 2030—o Futuro Da Agricultura Brasileira; MBRAPA: Brasilia, Brazil, 2018; ISBN 978-85-7035-799-1. [Google Scholar]
- Silva, M.d.G.C.; Medeiros, A.O.; Converti, A.; Almeida, F.C.G.; Sarubbo, L.A. Biosurfactants: Promising biomolecules for agricultural applications. Sustainability 2024, 16, 449. [Google Scholar] [CrossRef]
- Dehnert, G.K.; Freitas, M.B.; Sharma, P.P.; Barry, T.P.; Karasov, W.H. Impacts of subchronic exposure to a commercial 2,4-D herbicide on developmental stages of multiple freshwater fish species. Chemosphere 2021, 263, 127638. [Google Scholar] [CrossRef] [PubMed]
- Zhang, C.; Zhou, T.; Xu, Y.; Du, Z.; Li, B.; Wang, J.; Wang, J.; Zhu, L. Ecotoxicology of strobilurin fungicides. Sci. Total Environ. 2020, 742, 140611. [Google Scholar] [CrossRef] [PubMed]
- Calista, N.; Haikael, M.D.; Athanasia, M.O.; Neema, K.; Judith, K. Does pesticide exposure contribute to the growing burden of non-communicable diseases in Tanzania. Sci. Afr. 2022, 17, e01276. [Google Scholar] [CrossRef]
- Campalhola, C.; Bettiol, W. Métodos Alternativos de Controle Fitossanitário, 1st ed.; EMBRAPA: Jaguariúna, São Paulo, Brazil, 2003; ISBN 85-85771-22-4. [Google Scholar]
- Ward, L.T.; Hladik, M.L.; Guzman, A.; Winsemius, S.; Bautista, A.; Kremen, C.; Mills, N.J. Pesticide exposure of wild bees and honey bees foraging from field border flowers in intensively managed agriculture areas. Sci. Total Environ. 2022, 831, 154697. [Google Scholar] [CrossRef]
- Bailey, K.L.; Boyetchko, S.M.; Längle, T. Social and economic drivers shaping the future of biological control: A Canadian perspective on the factors affecting the development and use of microbial biopesticides. Biol. Control 2010, 52, 221–229. [Google Scholar] [CrossRef]
- Cavalcante, B.D.M.; Scapini, T.; Camargo, A.F.; Ulrich, A.; Bonatto, C.; Dalastra, C.; Mossi, A.J.; Fongaro, G.; Di Piero, R.M.; Treichel, H. Orange peels and shrimp shell used in a fermentation process to produce an aqueous extract with bioherbicide potential to weed control. Biocatal. Agric. Biotechnol 2021, 32, 101947. [Google Scholar] [CrossRef]
- Ulrich, A.; Lerin, L.A.; Camargo, A.F.; Scapini, T.; Diering, N.L.; Bonafin, F.; Gasparetto, I.G.; Confortin, T.C.; Sansonovicz, P.F.; Fabian, R.L.; et al. Alternative bioherbicide based on Trichoderma koningiopsis: Enzymatic characterization and its effect on cucumber plants and soil organism. Biocatal. Agric. Biotechnol. 2021, 36, 102127. [Google Scholar] [CrossRef]
- Acheuk, F.; Basiouni, S.; Shehata, A.A.; Dick, K.; Hajri, H.; Lasram, S.; Yilmaz, M.; Emekci, M.; Tsiamis, G.; Spona-Friedl, M.; et al. Status and prospects of botanical biopesticides in Europe and Mediterranean countries. Biomolecules 2022, 12, 311. [Google Scholar] [CrossRef]
- Mann, R.M.; Bidwell, J.R. The acute toxicity of agricultural surfactants to the tadpoles of four Australian and two exotic frogs. Environ. Pollut. 2001, 114, 195–205. [Google Scholar] [CrossRef] [PubMed]
- Sangwan, K.S.; Kshirsagar, V.D.; Parande, M.A.; Salunke, N.M.; Solanki, K.H.; Tambe, M.P.; Pundkar, D. Knowledge, attitude and practices regarding nutrition among pregnant females visiting the antenatal care outpatient department of a tertiary care hospital, pune. Int. J. Community Med. Public Health 2022, 9, 902. [Google Scholar] [CrossRef]
- MarketsandMarkets. Agricultural surfactants market worth $1.88 bn by 2022. Focus Surfactants 2018, 5, 2–3. [Google Scholar] [CrossRef]
- Crouzet, J.; Arguelles-Arias, A.; Dhondt-Cordelier, S.; Cordelier, S.; Pršić, J.; Hoff, G.; Mazeyrat-Gourbeyre, F.; Baillieul, F.; Clément, C.; Ongena, M.; et al. Biosurfactants in plant protection against diseases: Rhamnolipids and lipopeptides case study. Front. Bioeng. Biotechnol. 2020, 8, 1014. [Google Scholar] [CrossRef] [PubMed]
- Farias, C.B.B.; Almeida, F.C.G.; Silva, I.A.; Souza, T.C.; Meira, H.M.; Soares da Silva, R.d.C.F.; Luna, J.M.; Santos, V.A.; Converti, A.; Banat, I.M.; et al. Production of green surfactants: Market prospects. Electron. J. Biotechnol. 2021, 51, 28–39. [Google Scholar] [CrossRef]
- Silva, E.J.; Correa, P.F.; Almeida, D.G.; Luna, J.M.; Rufino, R.D.; Sarubbo, L.A. Recovery of contaminated marine environments by biosurfactant-enhanced bioremediation. Colloids Surf. B Biointerfaces 2018, 172, 127–135. [Google Scholar] [CrossRef]
- Sivapathasekaran, C.; Sen, R. Origin, properties, production and purification of microbial surfactants as molecules with immense commercial potential. Tenside Surfact. Det. 2017, 54, 92–104. [Google Scholar] [CrossRef]
- Maldaner, J.; Oliveira, M.N.; De Alexandria Santos, D.; Simote Silva, S.Y.; Da Cruz Silva, S.; Da Costa Lima, T.; Da Silva, M.L.; Lima Silva, H.T.; Siqueira-Silva, D.H.; Pauli kist Steffen, G.; et al. Bioherbicide and anesthetic potential of Aniba canelilla essential oil, a contribution to the demands of the agricultural sector. Biocatal. Agric. Biotechnol. 2022, 42, 102353. [Google Scholar] [CrossRef]
- Serrano-Carreón, L.; Aranda-Ocampo, S.; Balderas-Ruíz, K.A.; Juárez, A.M.; Leyva, E.; Trujillo-Roldán, M.A.; Val-dez-Cruz, N.A.; Galindo, E. A case study of a profitable mid-tech greenhouse for the sustainable production of tomato, using a biofertilizer and a biofungicide. Electron. J. Biotechnol. 2022, 59, 13–24. [Google Scholar] [CrossRef]
- Shokouhi, D.; Seifi, A. Organic extracts of seeds of iranian moringa peregrina as promising selective biofungicide to control mycogone perniciosa. Biocatal. Agric. Biotechnol. 2020, 30, 101848. [Google Scholar] [CrossRef]
- Fenibo, E.O.; Ijoma, G.N.; Matambo, T. Biopesticides in sustainable agriculture: Current status and future prospects. In New and Future Development in Biopesticide Research: Biotechnological Exploration; De Mandal, S., Ramkumar, G., Karthi, S., Jin, F., Eds.; Springer: Singapore, 2022; pp. 1–53. [Google Scholar] [CrossRef]
- Fenibo, E.O.; Ijoma, G.N.; Matambo, T. Biopesticides in sustainable agriculture: A critical sustainable development driver governed by green chemistry principles. Front. Sustain. Food Syst. 2021, 5, 619058. [Google Scholar] [CrossRef]
- Hipólito, A.; Alves da Silva, R.A.; Caretta, T.d.O.; Silveira, V.A.I.; Amador, I.R.; Panagio, L.A.; Borsato, D.; Celligoi, M.A.P.C. Evaluation of the antifungal activity of sophorolipids from Starmerella bombicola against food spoilage fungi. Biocatal. Agric. Biotechnol. 2020, 29, 101797. [Google Scholar] [CrossRef]
- Wadekar, S.D.; Kale, S.B.; Lali, A.M.; Bhowmick, D.N.; Pratap, A.P. Utilization of sweetwater as a cost-effective carbon source for sophorolipids production by Starmerella bombicola (ATCC 22214). Prep. Biochem. Biotechnol. 2012, 42, 125–142. [Google Scholar] [CrossRef] [PubMed]
- Smyth, T.J.P.; Perfumo, A.; Marchant, R.; Banat, I.M. Isolation and analysis of low molecular weight microbial glycolipids. In Handbook of Hydrocarbon and Lipid Microbiology; Timmis, K.M., Ed.; Springer: Singapore, 2010; pp. 3705–3723. [Google Scholar] [CrossRef]
- Mangalagiri, N.P.; Panditi, S.K.; Jeevigunta, N.L.L. Antimicrobial activity of essential plant oils and their major components. Heliyon 2021, 7, e06835. [Google Scholar] [CrossRef]
- Barnett, H.L.; Hunter, B.B. Illustrated Genera of Imperfect Fungi, 4th ed.; APS Press: Saint Paul, MN, USA, 1998; Volume 1. [Google Scholar]
- Yerushalmi, L.; Rocheleau, S.; Cimpoia, R.; Sarrazin, M.; Sunahara, G.; Peisajovich, A.; Leclair, G.; Guiot, S.R. Enhanced biodegradation of petroleum hydrocarbons in contaminated soil. Bioremediation J. 2003, 7, 37–51. [Google Scholar] [CrossRef]
- Yu, X.; Li, X.; Jin, T.; Su, Y.; Li, J.; Gao, M.; Zheng, L.; Tan, S.; Chen, G. Integrated biorefinery process for production of sophorolipids from corn straw. Biochem. Eng. J. 2021, 167, 107908. [Google Scholar] [CrossRef]
- Taowkrue, E.; Songdech, P.; Maneerat, S.; Soontorngun, N. Enhanced production of yeast biosurfactant sophorolipids using yeast extract or the alternative nitrogen source soybean meal. Ind. Crops Prod. 2024, 210, 118089. [Google Scholar] [CrossRef]
- Sarubbo, L.A.; Silva, M.G.C.; Durval, I.J.B.; Bezerra, K.G.O.; Ribeiro, B.G.; Silva, I.A.; Twigg, M.S.; Banat, I.M. Biosurfactants: Production, properties, applications, trends, and general perspectives. Biochem. Eng. J. 2022, 181, 108377. [Google Scholar] [CrossRef]
- Asmer, H.; Lang, S.; Wagner, F.; Wray, V. Microbial production, structure elucidation and bioconversion of sophorose lipids. J. Am. Oil Chem. Soc. 1988, 65, 1460–1466. [Google Scholar] [CrossRef]
- Konishi, M.; Morita, T.; Fukuoka, T.; Imura, T.; Uemura, S.; Iwabuchi, H.; Kitamoto, D. Efficient production of acid-form sophorolipids from waste glycerol and fatty acid methyl esters by Candida floricola. J. Oleo Sci. 2018, 67, 489–496. [Google Scholar] [CrossRef]
- Wang, H.; Roelants, S.L.; To, M.H.; Patria, R.D.; Kaur, G.; Lau, N.S.; Lau, C.Y.; Van Bogaert, I.N.; Soetaert, W.; Lin, C.S. Starmerella bombicola: Recent advances on sophorolipid production and prospects of waste stream utilization. J. Chem. Technol. Biotechnol. 2019, 94, 999–1007. [Google Scholar] [CrossRef]
- Gautam, K.K.; Tyagi, V.K. Microbial surfactants: A review. J. Oleo Sci. 2006, 55, 155–166. [Google Scholar] [CrossRef]
- Liu, Z.; Tian, X.; Chen, Y.; Lin, Y.; Mohsin, A.; Chu, J. Efficient sophorolipids production via a novel in situ separation technology by Starmerella bombicola. Process Biochem. 2019, 81, 1–10. [Google Scholar] [CrossRef]
- Satpute, S.K.; Płaza, G.A.; Banpurkar, A.G. Biosurfactants’ production from renewable natural resources: Example of innovative and smart technology in circular bioeconomy. Manag. Syst. Prod. Eng. 2017, 25, 46–54. [Google Scholar] [CrossRef]
- Roelants, S.L.K.W.; Ciesielska, K.; De Maeseneire, S.L.; Moens, H.; Everaert, B.; Verweire, S.; Denon, Q.; Vanlerberghe, B.; Van Bogaert, I.N.A.; Van Der Meeren, P.; et al. Towards the industrialization of new biosurfactants: Biotechno-logical opportunities for the lactone esterase gene from Starmerella bombicola. Biotechnol. Bioeng. 2016, 113, 550–559. [Google Scholar] [CrossRef]
- Dolman, B.M.; Kaisermann, C.; Martin, P.J.; Winterburn, J.B. Integrated sophorolipid production and gravity separation. Process Biochem. 2017, 54, 162–171. [Google Scholar] [CrossRef]
- Jeevanandam, J.; Adetunji, C.O.; Selvam, J.D.; Anani, O.A.; Inobeme, A.; Islam, S.; Thangadurai, D.; Olaniyan, O.T. High industrial beneficial microorganisms for effective production of a high quantity of biosurfactant. In Green Sustainable Process for Chemical and Environmental Engineering and Science; Inamuddin, C.O.A., Abdullah, M.A., Eds.; Elsevier: Amsterdam, The Netherlands, 2021; pp. 279–297. [Google Scholar] [CrossRef]
- Gao, S.; Liu, G.; Li, J.; Chen, J.; Li, L.; Li, Z.; Zhang, X.; Zhang, S.; Thorne, R.F.; Zhang, S. Antimicrobial activity of lemongrass essential oil (Cymbopogon flexuosus) and its active component citral against dual-species biofilms of Staphylococcus aureus and Candida species. Front. Cell. Infect. Microbiol. 2020, 10, 603858. [Google Scholar] [CrossRef]
- Abubacker, M.N.; Devi, P.K. In vitro antifungal potentials of bioactive compound oleic acid, 3-(octadecyloxy) propyl ester isolated from Lepidagathis cristata Willd. (Acanthaceae) inflorescence. Asian Pac. J. Trop. Med. 2014, 7, S190–S193. [Google Scholar] [CrossRef]
- Assadpour, E.; Can Karaça, A.; Fasamanesh, M.; Mahdavi, S.A.; Shariat-Alavi, M.; Feng, J.; Kharazmi, M.S.; Rehman, A.; Jafari, S.M. Application of essential oils as natural biopesticides: Recent advances. Crit. Rev. Food Sci. Nutr. 2024, 64, 6477–6497. [Google Scholar] [CrossRef]
- Fernandez, L.; Campbell, B.; Koivunen, M.; Marrone, P.G.; Huang, H. A Natural Herbicide Containing Lemongress Essential Oil 2008. Word Patent Number WO/2009/049153, 10 October 2008. [Google Scholar]
- Lameri, P. Use of Vegetable Oil as an Adjuvant for Substances Having a Fungicide, Bactericide, Insecticide and Herbicide Activity 2003. World Patent Number WO2003086073A1, 23 October 2003. [Google Scholar]
- Nalini, S.; Parthasarathi, R.; Inbakanadan, D. Biosurfactant in food and agricultural application. In Environmental Biotechnology; Gothandam, K.M., Ranjan, S., Dasgupta, N., Lichtfouse, E., Eds.; Springer: Singapore, 2020; pp. 75–94. [Google Scholar] [CrossRef]
- Chen, J.; Liu, X.; Fu, S.; An, Z.; Feng, Y.; Wang, R.; Ji, P. Effects of sophorolipids on fungal and oomycete pathogens in relation to pH solubility. J. Appl. Microbiol. 2020, 128, 1754–1763. [Google Scholar] [CrossRef]
- Bamgbose, I.; Anderson, T.A. Phytotoxicity of three plant-based biodiesels, unmodified castor oil, and diesel fuel to alfalfa (Medicago sativa L.), lettuce (Lactuca sativa L.), radish (Raphanus sativus), and wheatgrass (Triticum aestivum). Ecotoxicol. Environ. Saf. 2015, 122, 268–274. [Google Scholar] [CrossRef] [PubMed]
- Reis, A.; Lima, M.F.; Lopes, C.A.; Pinheiro, J.B. Principais Doenças do Maxixeiro; EMBRAPA: Brasilia, Brazil, 2015; pp. 1–10. ISSN 1415-3033. [Google Scholar]
- Singh, R.; Glick, B.R.; Rathore, D. Biosurfactants as a biological tool to increase micronutrient availability in soil: A review. Pedosphere 2018, 28, 170–189. [Google Scholar] [CrossRef]
- de O Caretta, T.; Silveira, V.A.I.; Andrade, G.; Macedo, F., Jr.; Celligoi, M.A.P.C. Antimicrobial activity of sophorolipids produced by Starmerella bombicola against phytopathogens from cherry tomato. J. Sci. Food Agric. 2022, 102, 1245–1254. [Google Scholar] [CrossRef] [PubMed]
- Lin, H.; Zhou, H.; Xu, L.; Zhu, H.; Huang, H. Effect of surfactant concentration on the spreading properties of pesticide droplets on eucalyptus leaves. Biosyst. Eng. 2016, 143, 42–49. [Google Scholar] [CrossRef]
- Burch, A.Y.; Zeisler, V.; Yokota, K.; Schreiber, L.; Lindow, S.E. The hygroscopic biosurfactant syringafactin produced by Pseudomonas syringae enhances fitness on leaf surfaces during fluctuating humidity. Environ. Microbiol. 2014, 16, 2086–2098. [Google Scholar] [CrossRef]
- Allai, F.M.; Azad, Z.R.A.A.; Mir, N.A.; Gul, K. Recent advances in non-thermal processing technologies for enhancing shelf life and improving food safety. Appl. Food Res. 2023, 3, 100258. [Google Scholar] [CrossRef]

| Treatment | Composition |
|---|---|
| T1 | Biosurfactant + oleic acid + distilled water |
| T2 | Biosurfactant + lemongrass oil + distilled water |
| T3 | Biosurfactant + tea tree oil + distilled water |
| T4 | Biosurfactant + castor oil + distilled water |
| T5 | Biosurfactant + commercial neem |
| T6 | Commercial neem |
| T7 | Distilled water (control) |
| T8 | Biosurfactant + distilled water |
| Treatment | Root Length (mm) |
|---|---|
| T1 | 5.0 ± 3.2 d |
| T2 | 0.0 ± 0.0 d |
| T3 | 0.0 ± 0.0 d |
| T4 | 21.4 ± 14.0 c |
| T5 | 5.0 ± 1.8 d |
| T6 | 34.8 ± 26.4 b |
| T7 | 48.3 ± 15.2 a |
| T8 | 2.4 ± 2.48 d |
| Treatment | Root Length (mm) |
|---|---|
| T1 | 60.98 ± 1.78 b,c |
| T2 | 50.29 ± 0.50 d |
| T3 | 74.42 ± 3.79 a |
| T4 | 59.27 ± 2.83 c |
| T5 | 63.96 ± 1.91 b |
| T6 | 58.13 ± 0.51 c |
| T7 | 40.21 ± 2.14 e |
| T8 | 57.64 ± 0.84 c |
Disclaimer/Publisher’s Note: The statements, opinions and data contained in all publications are solely those of the individual author(s) and contributor(s) and not of MDPI and/or the editor(s). MDPI and/or the editor(s) disclaim responsibility for any injury to people or property resulting from any ideas, methods, instructions or products referred to in the content. |
© 2024 by the authors. Licensee MDPI, Basel, Switzerland. This article is an open access article distributed under the terms and conditions of the Creative Commons Attribution (CC BY) license (https://creativecommons.org/licenses/by/4.0/).
Share and Cite
de Medeiros, A.O.; da Silva, M.d.G.C.; Converti, A.; de Almeida, F.C.G.; Sarubbo, L.A. Development of Natural Fungicidal Agricultural Defensives Using Microbial Glycolipid and Vegetable Oil Blends. Surfaces 2024, 7, 879-897. https://doi.org/10.3390/surfaces7040058
de Medeiros AO, da Silva MdGC, Converti A, de Almeida FCG, Sarubbo LA. Development of Natural Fungicidal Agricultural Defensives Using Microbial Glycolipid and Vegetable Oil Blends. Surfaces. 2024; 7(4):879-897. https://doi.org/10.3390/surfaces7040058
Chicago/Turabian Stylede Medeiros, Anderson O., Maria da Gloria C. da Silva, Attilio Converti, Fabiola Carolina G. de Almeida, and Leonie A. Sarubbo. 2024. "Development of Natural Fungicidal Agricultural Defensives Using Microbial Glycolipid and Vegetable Oil Blends" Surfaces 7, no. 4: 879-897. https://doi.org/10.3390/surfaces7040058
APA Stylede Medeiros, A. O., da Silva, M. d. G. C., Converti, A., de Almeida, F. C. G., & Sarubbo, L. A. (2024). Development of Natural Fungicidal Agricultural Defensives Using Microbial Glycolipid and Vegetable Oil Blends. Surfaces, 7(4), 879-897. https://doi.org/10.3390/surfaces7040058

